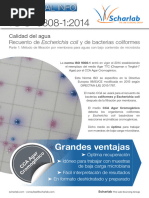

Control de calidad disponible mundialmente
Nuestro objetivo es suministrarle productos de primera calidad, un servicio excelente,
entregas rápidas y una asistencia técnica sobresaliente a fin de superar sus expectativas.
Thermo Scientific Culti-Loops
Servicio de atención al cliente
Microorganismos de control de calidad
Nuestro equipo de atención al cliente está dispuesto a ayudarle a realizar los pedidos y a proporcionarle la
información que precise para adquirir microorganismos para control de calidad.
Asistencia técnica
Nuestro equipo de asistencia técnica está compuesto por profesionales de gran experiencia y amplia
formación que le asesorarán con la información técnica, incluido el uso y los resultados esperados de los
microorganismos para control de calidad.
Si es un cliente internacional, para recibir asistencia visite www.thermoscientific.com/oxoid-techsupport
Si es un cliente de los EE. UU., para recibir asistencia visite www.thermoscientific.com/remel-techsupport
Microorganismos con un control de calidad a su medida
Trabajaremos con usted para desarrollar un microorganismo para control de calidad personalizado que se
ajuste a sus necesidades específicas. Póngase en contacto con el representante de ventas local para solicitar
más información.
Visite nuestro buscador Look-Up Tool en www.remel.com/support/qclookup.aspx y seleccione
El mejor modo
rápidamente por género, especie o número de referencia ATCC®.
de supervisar la calidad
®
El emblema ATCC Licensed Derivative, la marca ATCC Licensed Derivative y las marcas de
catálogo ATCC son marcas registradas de ATCC. Thermo Fisher Scientific tiene licencia para
usar estas marcas comerciales y para vender productos derivados de cultivos ATCC®. Busque el
emblema ATCC Licensed Derivative® para productos derivados de cultivos ATCC®.
thermoscientific.com/oxoid
© 2012 Thermo Fisher Scientific. Reservados todos los derechos. ATCC® es una marca registrada de ATCC. Las demás marcas comerciales son propiedad de Thermo
Fisher Scientific Inc. y sus filiales.
Información de contacto:
Internacional Estados Unidos
+44 (0) 1256 841144 +1 800 225 6730
oxoid.info@thermofisher.com csemail@thermofisher.com LT2047A
�Del asa a la placa Sin necesidad de rehidratación
Las Culti-Loops de Thermo Scientific son asas bacteriológicas desechables listas para ser
utilizadas, que contienen microorganismos viables y estabilizados en una matriz de gel especial.
Comodidad
Reduzca el tiempo y los costes innecesarios en recursos de laboratorio con un asa de inoculación de
siembra directa que no requiere rehidratación. 1 2 3
Prestaciones
Obtenga una mayor viabilidad y recuperación con los microorganismos conservados en nuestro gel
FPO FPO FPO
especializado.
Valor
Consolide el tiempo dedicado a realizar pedidos y los gastos de envío poniéndose en las manos
de un único proveedor que ofrece medios de cultivo y microorganismos para control de calidad Abra el paquete Aplique al agar Incube
excelentes. templado
Seguridad
Logre una trazabilidad absoluta gracias a las cepas ATCC® License Derivative.
Un control de calidad riguroso garantiza los resultados de las pruebas clínicas así como
Eficiencia la reproducibilidad de la evaluación microbiológica de los productos farmaceuticos y
Consiga una documentación precisa y cómoda gracias a las etiquetas despegables y transferibles. alimentarios, lo que nos permite lograr eficacia y alto rendimiento. Para obtener unos
resultados de calidad en los que pueda basarse, confíe en los microorganismos para
Seguridad
Reduzca los riesgos de contaminación e infección gracias a una ausencia total de manipulación de control de calidad de Thermo Scientific, respaldado por más de 30 años de experiencia.
microorganismos.
• Más de 600 microorganismos para control de calidad, incluidas las series aptas para
sistemas de identificación
Los cultivos Culti-Loops™ se fabrican mediante una tecnología • Certificación ISO, conforme a cGMP (Buenas prácticas de elaboración actuales),
especializada de conservación en gel que ofrece ventajas únicas registrado en la FDA
sobre los microorganismos liofilizados, entre las que se incluyen:
recuperación más rápida, mayor viabilidad y capacidad de utilización • Miembro del ATCC® Licensed Derivative Program
directa del asa a la placa.
Una recuperación más eficiente de los microorganismos ahorra
tiempo y recursos al laboratorio.
Para recuperar el microorganismo, basta con humedecer la película
de gel colocando el asa de siembra directamente sobre la placa de
agar templado durante 10–15 segundos.